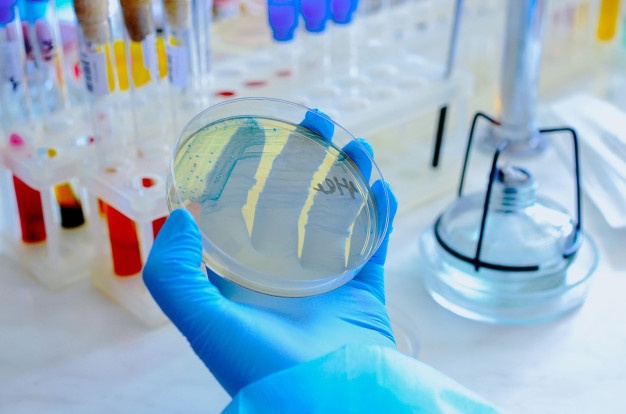

Utilizamos tecnologías como cookies para almacenar y/o acceder a información del dispositivo. Al consentir su uso, podremos procesar datos como el comportamiento de navegación. No dar tu consentimiento puede afectar ciertas funciones del sitio.
El almacenamiento técnico o acceso es estrictamente necesario para el propósito legítimo de habilitar el uso de un servicio específico solicitado explícitamente por el suscriptor o usuario, o para el único propósito de llevar a cabo la transmisión de una comunicación a través de una red de comunicaciones electrónicas.
The technical storage or access is necessary for the legitimate purpose of storing preferences that are not requested by the subscriber or user.
The technical storage or access that is used exclusively for statistical purposes.
El almacenamiento técnico o acceso que se utiliza exclusivamente con fines estadísticos anónimos. Sin una orden judicial, cumplimiento voluntario por parte de su proveedor de servicios de Internet, o registros adicionales de un tercero, la información almacenada o recuperada para este único propósito generalmente no puede usarse para identificarlo.
El almacenamiento técnico o acceso es necesario para crear perfiles de usuario con el fin de enviar publicidad, o para rastrear al usuario en un sitio web o en varios sitios web con fines similares de marketing.